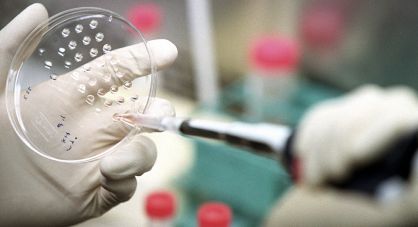

Sánchez afronta hoy su primer debate sobre la línea ideológica del PSOE
La corriente Izquierda Socialista pedirá ante el comité federal “no demonizar” a Podemos ni colocarle junto al PP. El secretario general oficializará su candidatura a la presidencia del Gobierno